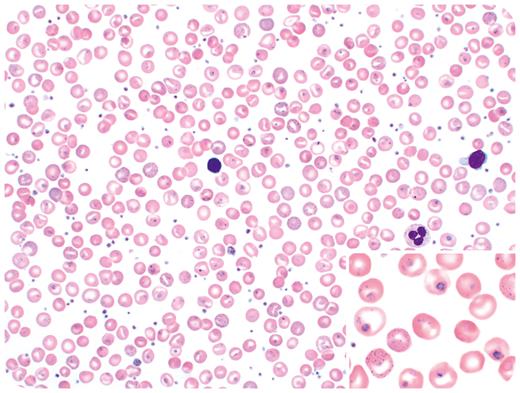
graphic

A 58-year-old woman presented for a routine annual exam. A complete blood count showed moderate macrocytic anemia (hemoglobin, 9.0 g/dL; mean corpuscular volume, 127 fL) and thrombocytosis (633 000/μL). Her vitamin B12 and folate levels were normal. Peripheral smear showed increased polychromasia, basophilic stippling, Howell-Jolly bodies, and Pappenheimer bodies (Wright-Giemsa stain, 50× objective, total magnification ×500). Additionally, some red blood cells (RBCs) showed pleomorphic ring-like forms with purple dots, resembling a parasitic infection by Babesia or Plasmodium spp (inset, 100× objective, total magnification ×1000). Thorough exploration into the patient’s past medical history revealed that she was diagnosed with hemoglobin Southampton at 1 year of age and had a splenectomy at age 4 years.
Hemoglobin Southampton (Casper) is a rare, unstable hemoglobinopathy caused by a point mutation in the HBB gene (c. 320T>C, p.L107P) resulting in distortion of the tertiary structure of the hemoglobin molecule, leading to membrane damage and RBC destruction. Hepatosplenomegaly, chronic hemolytic anemia, and methemoglobinemia are common features. Macrocytosis is sometimes observed, and evaluation for vitamin B12 and folate deficiency is recommended due to chronic hemolysis and the constant regenerative nature of the bone marrow. Splenectomy helps decrease the transfusion requirement and chronic hemolysis. This case highlights the importance of obtaining patient history and clinical symptoms when reviewing blood smears, as RBC inclusions in these rare unstable hemoglobinopathies can be mistaken for parasitic infections.
For additional images, visit the ASH Image Bank, a reference and teaching tool that is continually updated with new atlas and case study images. For more information, visit https://imagebank.hematology.org.

This feature is available to Subscribers Only
Sign In or Create an Account Close Modal